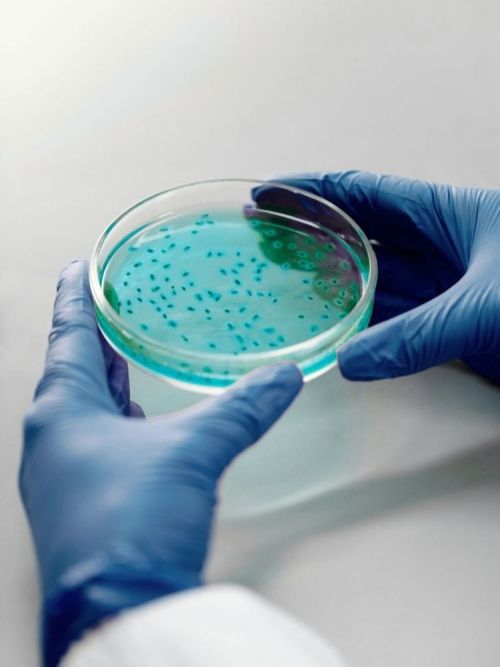

Credito d’Imposta Ricerca e Sviluppo
Molti imprenditori credono che la “Ricerca e Sviluppo” sia un’attività riservata a scienziati in camice bianco o a grandi multinazionali. Non è così.
Nel settore industriale, la R&S non vive nei laboratori, ma nelle tue officine e nei tuoi uffici tecnici.
Stai facendo Ricerca e Sviluppo ogni volta che:
- Progetti un nuovo componente o un prototipo che prima non esisteva.
- Migliori le prestazioni tecniche di un prodotto già in catalogo.
- Testi nuovi materiali per rendere i tuoi prodotti più resistenti o leggeri.
- Risolvi un problema tecnico complesso che bloccava la produzione.
- Migliori i tuoi processi aziendali con soluzioni innovative
Queste attività non sono “semplice lavoro quotidiano”: sono innovazioni che lo Stato premia con il Credito d’Imposta R&S.
Il nostro compito? Aiutarti a riconoscere queste attività e trasformarle in un risparmio fiscale certo. Con la Certificazione di E3 Group, mettiamo in sicurezza i tuoi progetti.
Il Credito d’Imposta Ricerca e Sviluppo (R&S) è uno dei principali strumenti a supporto degli investimenti in innovazione, sviluppo tecnologico e competitività delle imprese.
E3 Group è regolarmente iscritta all’albo dei certificatori R&S, requisito che garantisce l’idoneità alla certificazione delle attività e delle spese, rafforzando la solidità e la difendibilità del credito d’imposta.
Supportiamo le aziende nell’accesso all’agevolazione attraverso un approccio tecnico e normativo, orientato alla massimizzazione del beneficio e alla riduzione del rischio fiscale.
Le aree di intervento agevolabili
Cos’è il Credito d’Imposta R&S
Il credito d’imposta R&S consente alle imprese di recuperare una quota delle spese sostenute per attività di:
- Ricerca fondamentale, attività teoriche o sperimentali finalizzate all’acquisizione di nuove conoscenze.
- Ricerca industriale, attività finalizzate allo sviluppo di nuovi prodotti, processi o servizi.
- Sviluppo sperimentale, progettazione, prototipazione e validazione di soluzioni innovative.
L’incentivo è riconosciuto sotto forma di credito fiscale compensabile, rappresentando una leva concreta per sostenere progetti ad alto contenuto tecnologico.

Ricerca fondamentale,
ricerca industriale e
sviluppo sperimentale

Innovazione Tecnologica

Innovazione tecnologica 4.0 e green

Design e Ideazione Estetica
Dalla stima alla certificazione
Criteri di ammissibilità (approccio tecnico)
La valutazione delle attività R&S viene effettuata secondo criteri rigorosi, in linea con i principali standard internazionali:
- Manuale di Frascati, per la definizione delle attività di ricerca e sviluppo;
- Manuale di Oslo, per l’inquadramento delle attività di innovazione.
Le attività svolte dall’impresa devono presentare:
Incertezza tecnico-scientifica reale;
Contenuto innovativo dimostrabile;
Processo strutturato di sviluppo e sperimentazione.
Spese ammissibili
Il credito si applica a diverse categorie di costo, tra cui:
- personale tecnico impiegato nelle attività di R&S;
- strumenti e attrezzature;
- contratti di ricerca esterni;
- consulenze tecniche e scientifiche;
- materiali utilizzati nei progetti.

E3 Group e il Credito d’Imposta Ricerca e Sviluppo (R&S)
Il nostro approccio
Affianchiamo le aziende lungo tutto il processo:
- analisi di ammissibilità tecnica: valutazione dei progetti secondo Manuale di Frascati e Oslo;
- identificazione e classificazione delle attività R&S:
- corretta distinzione tra ricerca e sviluppo;
- raccolta e strutturazione delle spese: definizione del perimetro economico;
- redazione della documentazione tecnica: predisposizione della relazione descrittiva dei progetti;
- certificazione R&S: rilascio della certificazione tramite soggetto iscritto all’albo;
- supporto in fase di controllo: assistenza completa in caso di verifiche.
Un approccio tecnico, non solo fiscale
Il Credito R&S richiede competenze interdisciplinari:
- ingegneristiche e scientifiche;
- normative e fiscali;
- organizzative e documentali.
Il valore che E3 Group cerca di trasmettere risiede nella capacità di tradurre attività tecniche complesse in documentazione conforme, strutturata e difendibile.
Il nostro impegno
E3 Group supporta le imprese nel trasformare un incentivo fiscale in un progetto concreto di innovazione.
Il nostro obiettivo è garantire conformità, sicurezza e massimizzazione del beneficio, riducendo i rischi e creando valore reale.
Richiedi una consulenza dedicata
Analizziamo i tuoi progetti di innovazione per garantirti la massima sicurezza fiscale e il pieno rispetto dei Manuali di Frascati e Oslo







